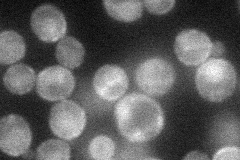
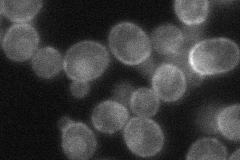

View description
Arf3p polarization-specific docking factor, required for the polarized distribution of the ADP-ribosylation factor, Arf3p; participates in polarity development and maintenance of a normal haploid budding pattern; interacts with Cnm7p
Localization:
Intensity:
Fold change:
Significance:
-
C’ GFP library in SD

below threshold16.41 -
N' NOP1pr-GFP in SD
cell periphery,nucleus37.5292 -
N' TEF2pr-mCherry in SD
cell periphery,nucleus31.1825 -
N' NATIVEpr-GFP in SD

below threshold19.8821 -
N' TEF2pr-VC and Cyto-VN in SD

#N/A0 -
C’ GFP library in SD+DTT

cytosol16.681.01No -
C’ GFP library in SD+H2O2

cytosol16.431No -
C’ GFP library in Starvation Media

cytosol14.510.88No -
C’ GFP library on the background of Pup2-DaMP

below threshold -
C’ GFP library on the background of CCT mutant

below threshold17.23371.04982No
